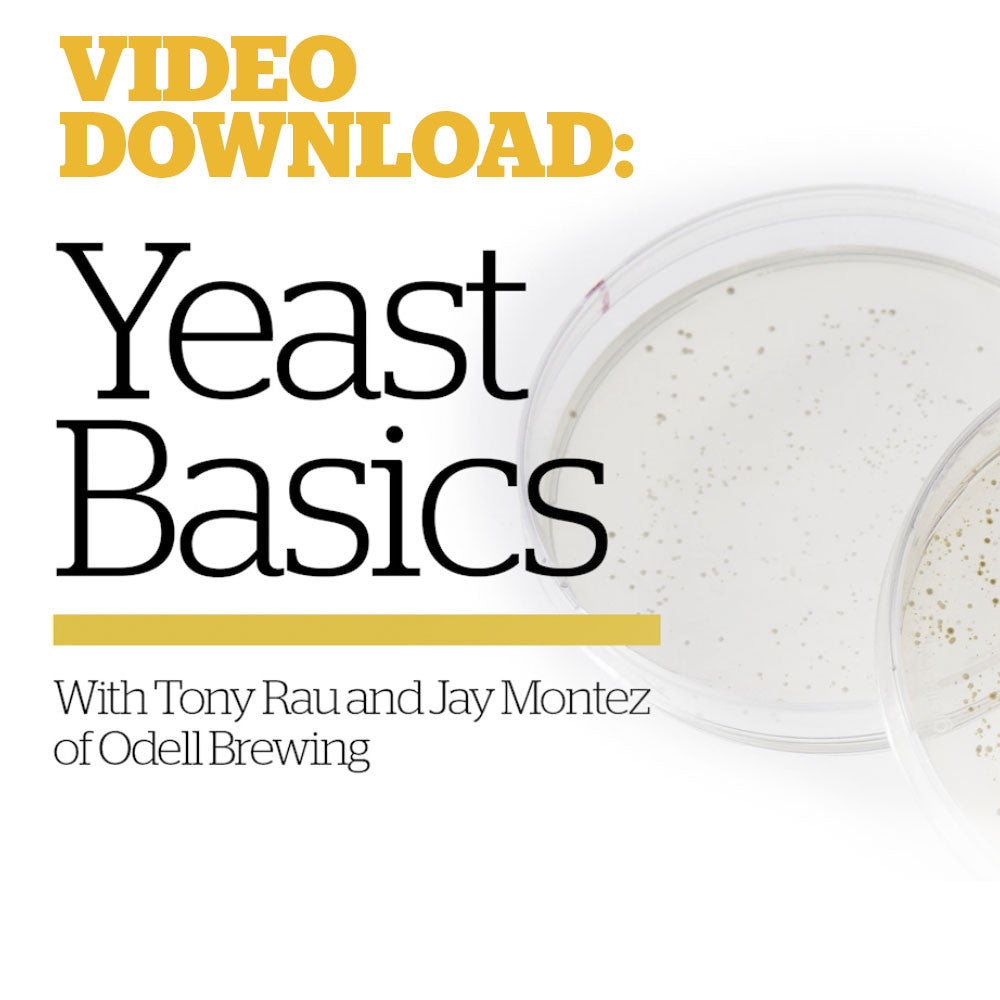
Basic Yeast Culturing & Banking (Video Download) - Craft Beer & Brewing

1
/
of
1
Basic Yeast Culturing & Banking (Video Download)
Basic Yeast Culturing & Banking (Video Download)
Regular price
$ 9.99 USD
Regular price
Sale price
$ 9.99 USD
Unit price
/
per
Couldn't load pickup availability
Join hosts Jay Montez and Tony Rau of Odell Brewing Company as they guides you through basic classes on how to use yeast like a pro. In this 22-minute video they cover
- How to create a yeast starter
- Washing, harvesting, and reusing yeast to save money and improve your brewing efficiency
Share